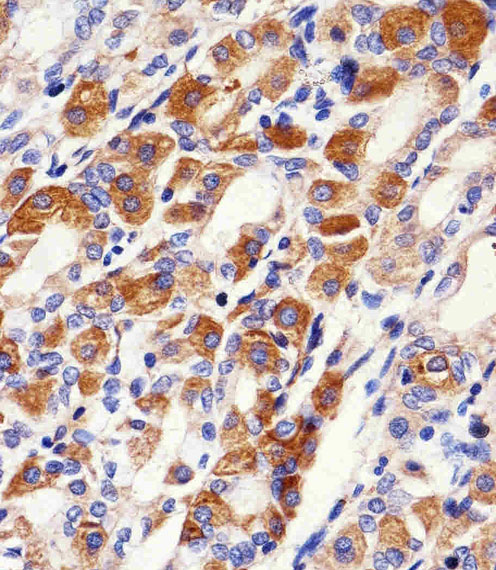

> Antigen, Antibodies, ELISA, Western Blot > Primary Antibody > Polyclonal Antibodies > PACSIN2 Antibody (C-term)Brand |
Leading Biology | Catalog Number |
APR14270G |
Product Type |
Polyclonal Antibodies | Field of Research |
|
Product Overview |
We constantly strive to ensure we provide our customers with the best antibodies. As a result of this work we offer this antibody in purified format.
We are in the process of updating our datasheets. If you have any questions regarding this update, please feel free to contact our technical support team.
This product is a high quality PACSIN2 antibody (C-term).
|
||
Molecular Weight |
55739 Da
|
||
Cellular Localization |
Antigen Cellular Localization:
Cytoplasm. Cytoplasm, cytoskeleton. Cytoplasmic vesicle membrane; Peripheral membrane protein; Cytoplasmic side. Early endosome Recycling endosome membrane. Cell projection, ruffle membrane; Peripheral membrane protein; Cytoplasmic side. Cell membrane; Peripheral membrane protein; Cytoplasmic side. Cell projection. Membrane, caveola. Note=Detected at the neck of flask-shaped caveolae. Localization to tubular recycling endosomes probably requires interaction with MICALL1 and EHD1
|
||
Host |
Rabbit
|
||
Species Reactivity |
Human, Mouse
|
||
Immunogen |
342-371 aa
|
||
Target |
This PACSIN2 antibody is generated from rabbits immunized with a KLH conjugated synthetic peptide between 342-371 amino acids from the C-terminal region of human PACSIN2.
|
||
Isotype |
Rabbit Ig
|
||
GeneID |
|||
UniProt ID |
|||
Function |
Lipid-binding protein that is able to promote the tubulation of the phosphatidic acid-containing membranes it preferentially binds. Plays a role in intracellular vesicle- mediated transport. Involved in the endocytosis of cell-surface receptors like the EGF receptor, contributing to its internalization in the absence of EGF stimulus. May also play a role in the formation of caveolae at the cell membrane. Recruits DNM2 to caveolae, and thereby plays a role in caveola-mediated endocytosis.
|
||
Summary |
PACSIN may play a role in vesicle formation and transport. This protein homo- and hetero-aggregates with other PACSINs. It also binds dynamin 1, synaptojanin, synapsin 1 and the neural Wiskott-Aldrich syndrome protein (N-WASP). The protein exhibits a cvesicle-like cytoplasmic distribution and is ubiquitously expressed. PACSIN is phosphorylated by casein kinase 2 (CK2) and protein kinase C (PKC). The protein contains 1 FCH domain and 1 SH3 domain.
|
||
Form |
Purified polyclonal antibody supplied in PBS with 0.09% (W/V) sodium azide. This antibody is purified through a protein A column, followed by peptide affinity purification. |
||
Storage & Stability |
Store at +4°C short term. For long-term storage, aliquot and store at -20°C or below. Stable for 12 months at -20°C. Avoid repeated freeze-thaw cycles.
|
||
Applications |
WB, IHC-P, IF, E
|
||
Dilution |
IHC-P~~1:50~100
IF~~1:100
WB~~1:1000
|
||
Synonyms |
Protein kinase C and casein kinase substrate in neurons protein 2, Syndapin-2, Syndapin-II, PACSIN2
|
||
Images |

Immunohistochemical analysis of paraffin-embedded H. stomach section using PACSIN2 Antibody (C-term)( APR14270G). APR14270G was diluted at 1:25 dilution. A peroxidase-conjugated goat anti-rabbit IgG at 1:400 dilution was used as the secondary antibody, followed by DAB staining.
Immunohistochemical analysis of paraffin-embedded H.stomach section using PACSIN2 Antibody (C-term)( APR14270G). APR14270G was diluted at 1:100 dilution. A peroxidase-conjugated goat anti-rabbit IgG at 1:400 dilution was used as the secondary antibody, followed by DAB staining. 
Immunofluorescent analysis of Hela cells, using PACSIN2 Antibody (C-term) (Cat. APR14270G). APR14270G was diluted at 1:100 dilution. Alexa Fluor? 488-conjugated goat anti-rabbit lgG at 1:400 dilution was used as the secondary antibody (green).Cytoplasmic actin was counterstained with Dylight Fluor? 554 (red) conjugated Phalloidin (red). |
||
Specification |
|||
Quantity |
|
||
| Select | Brand | Catalog No. | Product Name | Pack Size | Type | Field of Research | Specification | Quantity | Price(USD) | |
| 1 | Leading Biology | APR03440G | ITGA11 Antibody (N-term) | 100 μl | Polyclonal Antibodies |
|
$495.00 | Add Ask | ||
| 2 | Leading Biology | APR04537G | CMIP Antibody (C-term) | 100 μl | Polyclonal Antibodies |
|
$495.00 | Add Ask | ||
| 3 | Leading Biology | APR12422G | Human H4 Histamine Receptor (extracellular) Antibody | 50 μl | Polyclonal Antibodies |
|
$695.00 | Add Ask | ||
| 4 | Leading Biology | APR03844G | UBE2W Antibody (C-term) | 100 μl | Polyclonal Antibodies |
|
$495.00 | Add Ask | ||
| 5 | Leading Biology | APR04349G | HECTD2 Antibody (N-term) | 100 μl | Polyclonal Antibodies |
|
$495.00 | Add Ask | ||
| 6 | Leading Biology | APR03502G | IGHG1 Antibody (Center) | 100 μl | Polyclonal Antibodies |
|
$495.00 | Add Ask |
 Leading Biology Inc.
2600 Hilltop DR, Building G, B Suite C138
Richmond, CA, 94806
Tel: 1-661-524(LBI)-0262
Email: info@leadingbiology.com
Leading Biology Inc.
2600 Hilltop DR, Building G, B Suite C138
Richmond, CA, 94806
Tel: 1-661-524(LBI)-0262
Email: info@leadingbiology.com
Complete this form and click send to ask us a question, request a quote or simply say hello.

You have 0 item in your cart

You have 0 item in your inquiry list
